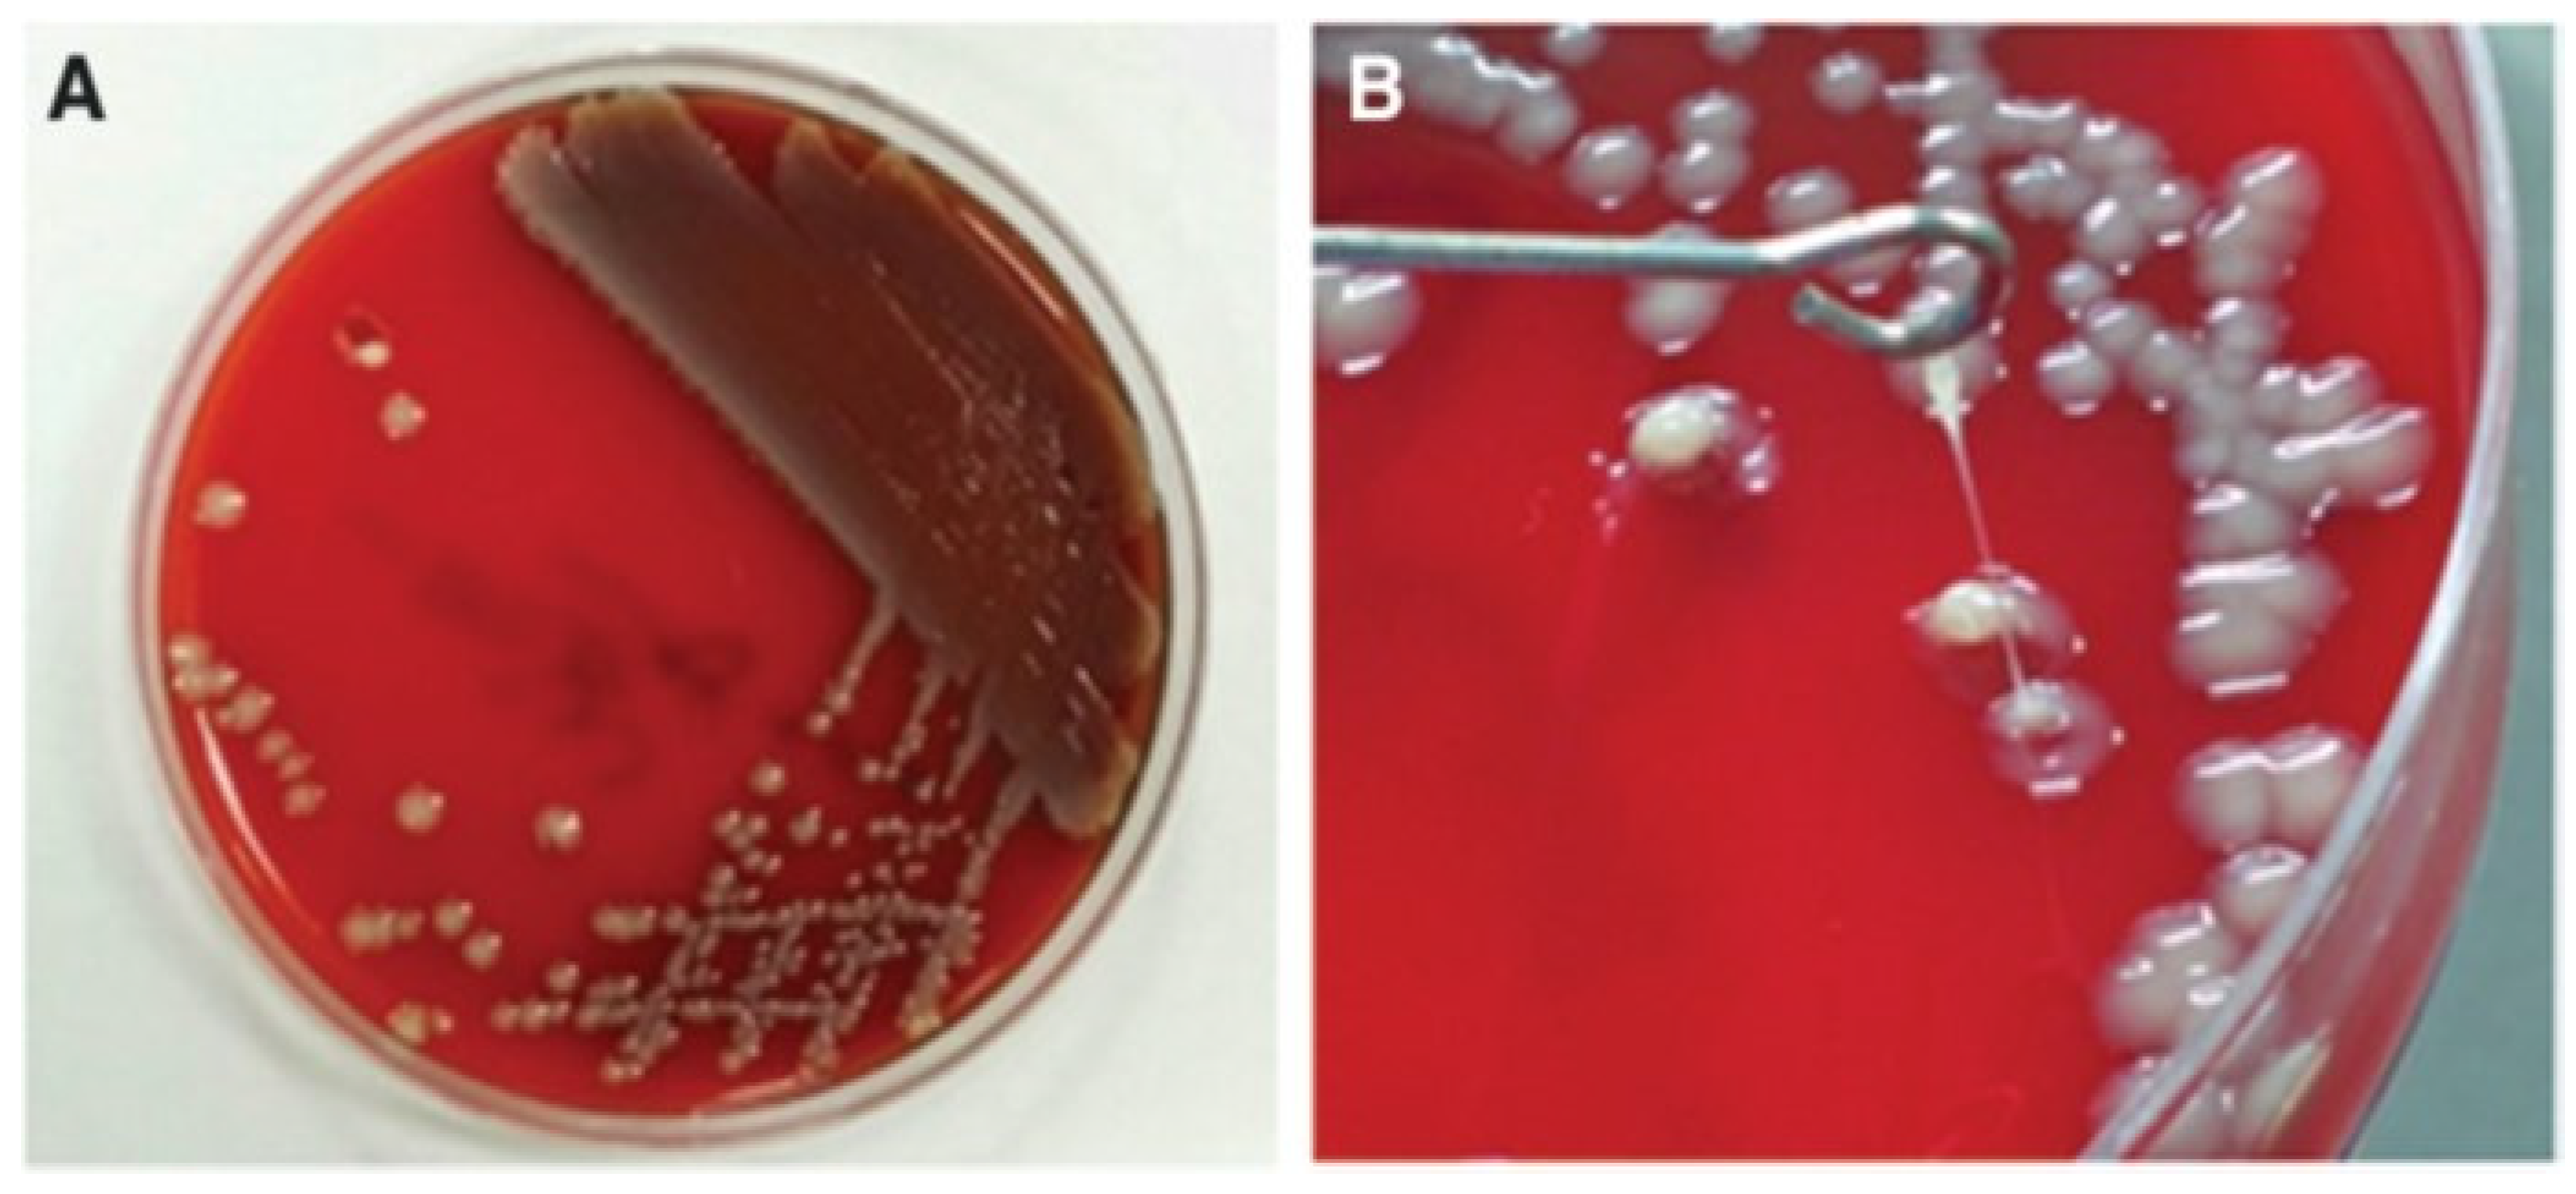

Clinical and Microbiologic Analysis of Klebsiella pneumoniae Infection: Hypermucoviscosity, Virulence Factor, Genotype, and Antimicrobial Susceptibility
Abstract
1. Introduction
2. Methods
2.1. Study Participants
2.2. Study Design
2.3. Definitions of Hypervirulent K. pneumoniae
2.4. Detection of K. pneumoniae Hypermucoviscosity
2.5. Polymerase Chain Reaction
2.6. Biofilm Formation
2.7. Antimicrobial Susceptibility Test
2.8. Statistical Analyses
3. Results
3.1. Clinical and Microbiological Characteristics According to Hypermucoviscosity
3.2. Clinical and Microbiological Characteristics According to Aerobactin Positivity
3.3. Epidemiology and Clinical characteristics According to Community-Acquired Liver Abscess
3.4. Antimicrobial Susceptibility and Microbiological Characteristics According to Community-Acquired Liver Abscess
3.5. Significant Virulence Factors for Community-Acquired Liver Abscess in K. pneumoniae
4. Discussion
Supplementary Materials
Author Contributions
Funding
Institutional Review Board Statement
Informed Consent Statement
Data Availability Statement
Acknowledgments
Conflicts of Interest
References
- Chang, F.Y.; Chou, M.Y.; Fan, R.L.; Shaio, M.F. A clinical study of Klebsiella liver abscess. Taiwan Yi Xue Hui Za Zhi 1988, 87, 282–287. [Google Scholar] [PubMed]
- Chang, F.Y.; Chou, M.Y. Comparison of pyogenic liver abscesses caused by Klebsiella pneumoniae and non-K. pneumoniae pathogens. J. Formos. Med. Assoc. 1995, 94, 232–237. [Google Scholar] [PubMed]
- Siu, L.K.; Yeh, K.M.; Lin, J.C.; Fung, C.P.; Chang, F.Y. Klebsiella pneumoniae liver abscess: A new invasive syndrome. Lancet Infect. Dis. 2012, 12, 881–887. [Google Scholar] [CrossRef] [PubMed]
- Liu, Y.C.; Cheng, D.L.; Lin, C.L. Klebsiella pneumoniae liver abscess associated with septic endophthalmitis. Arch. Intern Med. 1986, 146, 1913–1916. [Google Scholar] [CrossRef] [PubMed]
- Li, W.; Sun, G.; Yu, Y.; Li, N.; Chen, M.; Jin, R.; Jiao, Y.; Wu, H. Increasing occurrence of antimicrobial-resistant hypervirulent (hypermucoviscous) Klebsiella pneumoniae isolates in China. Clin. Infect. Dis. 2014, 58, 225–232. [Google Scholar] [CrossRef] [PubMed]
- Liu, Y.M.; Li, B.B.; Zhang, Y.Y.; Zhang, W.; Shen, H.; Li, H.; Cao, B. Clinical and molecular characteristics of emerging hypervirulent Klebsiella pneumoniae bloodstream infections in mainland China. Antimicrob. Agents Chemother. 2014, 58, 5379–5385. [Google Scholar] [CrossRef] [PubMed]
- Kong, Q.; Beanan, J.M.; Olson, R.; Macdonald, U.; Shon, A.S.; Metzger, D.J.; Pomakov, A.O.; Russo, T.A. Biofilm formed by a hypervirulent (hypermucoviscous) variant of Klebsiella pneumoniae does not enhance serum resistance or survival in an in vivo abscess model. Virulence 2012, 3, 309–318. [Google Scholar] [CrossRef] [PubMed]
- Casanova, C.; Lorente, J.A.; Carrillo, F.; Perez-Rodriguez, E.; Nunez, N. Klebsiella pneumoniae liver abscess associated with septic endophthalmitis. Arch. Intern Med. 1989, 149, 1467. [Google Scholar] [CrossRef]
- Fung, C.P.; Chang, F.Y.; Lee, S.C.; Hu, B.S.; Kuo, B.I.; Liu, C.Y.; Ho, M.; Siu, L.K. A global emerging disease of Klebsiella pneumoniae liver abscess: Is serotype K1 an important factor for complicated endophthalmitis? Gut 2002, 50, 420–424. [Google Scholar] [CrossRef]
- Moellering, R.C., Jr. NDM-1—A cause for worldwide concern. N. Engl. J. Med. 2010, 363, 2377–2379. [Google Scholar] [CrossRef]
- Conlan, S.; Thomas, P.J.; Deming, C.; Park, M.; Lau, A.F.; Dekker, J.P.; Snitkin, E.S.; Clark, T.A.; Luong, K.; Song, Y.; et al. Single-molecule sequencing to track plasmid diversity of hospital-associated carbapenemase-producing Enterobacteriaceae. Sci. Transl. Med. 2014, 6, 254ra126. [Google Scholar] [CrossRef] [PubMed]
- Russo, T.A.; Olson, R.; MacDonald, U.; Beanan, J.; Davidson, B.A. Aerobactin, but not yersiniabactin, salmochelin, or enterobactin, enables the growth/survival of hypervirulent (hypermucoviscous) Klebsiella pneumoniae ex vivo and in vivo. Infect. Immun. 2015, 83, 3325–3333. [Google Scholar] [CrossRef] [PubMed]
- Sheng, Z.; Li, J.; Chen, T.; Zhu, Y.; Yu, X.; He, X.; Zheng, Y.; Ma, C.; Zheng, M.; Wang, P.; et al. Clinical and Microbiological Characteristics of Klebsiella pneumoniae Bloodstream Infection in a Chinese Hospital: Hypervirulent and Multiclonal. Infect. Drug Resist. 2022, 15, 3981–3990. [Google Scholar] [CrossRef] [PubMed]
- Russo, T.A.; Olson, R.; Fang, C.T.; Stoesser, N.; Miller, M.; MacDonald, U.; Hutson, A.; Barker, J.H.; La Hoz, R.M.; Johnson, J.R. Identification of Biomarkers for Differentiation of Hypervirulent Klebsiella pneumoniae from Classical K. pneumoniae. J. Clin. Microbiol. 2018, 56, e00776-18. [Google Scholar] [CrossRef] [PubMed]
- Shankar, C.; Basu, S.; Lal, B.; Shanmugam, S.; Vasudevan, K.; Mathur, P.; Ramaiah, S.; Anbarasu, A.; Veeraraghavan, B. Aerobactin Seems To Be a Promising Marker Compared With Unstable RmpA2 for the Identification of Hypervirulent Carbapenem-Resistant Klebsiella pneumoniae: In Silico and In Vitro Evidence. Front. Cell. Infect. Microbiol. 2021, 11, 709681. [Google Scholar] [CrossRef] [PubMed]
- Liu, C.; Guo, J. Hypervirulent Klebsiella pneumoniae (hypermucoviscous and aerobactin positive) infection over 6 years in the elderly in China: Antimicrobial resistance patterns, molecular epidemiology and risk factor. Ann. Clin. Microbiol. Antimicrob. 2019, 18, 4. [Google Scholar] [CrossRef]
- Vandhana, V.; Saralaya, K.V.; Bhat, S.; Shenoy Mulki, S.; Bhat, A.K. Characterization of Hypervirulent Klebsiella pneumoniae (Hv-Kp): Correlation of Virulence with Antimicrobial Susceptibility. Int. J. Microbiol. 2022, 2022, 4532707. [Google Scholar] [CrossRef] [PubMed]
- Chen, Y.T.; Lai, Y.C.; Tan, M.C.; Hsieh, L.Y.; Wang, J.T.; Shiau, Y.R.; Wang, H.Y.; Lin, A.C.; Lai, J.F.; Huang, I.W.; et al. Prevalence and characteristics of pks genotoxin gene cluster-positive clinical Klebsiella pneumoniae isolates in Taiwan. Sci. Rep. 2017, 7, 43120. [Google Scholar] [CrossRef] [PubMed]
- Liu, Z.; Gu, Y.; Li, X.; Liu, Y.; Ye, Y.; Guan, S.; Li, J. Identification and Characterization of NDM-1-producing Hypervirulent (Hypermucoviscous) Klebsiella pneumoniae in China. Ann. Lab. Med. 2019, 39, 167–175. [Google Scholar] [CrossRef] [PubMed]
- Liu, C.; Shi, J.; Guo, J. High prevalence of hypervirulent Klebsiella pneumoniae infection in the genetic background of elderly patients in two teaching hospitals in China. Infect. Drug Resist. 2018, 11, 1031–1041. [Google Scholar] [CrossRef] [PubMed]
- Hyun, M.; Lee, J.Y.; Ryu, S.Y.; Ryoo, N.; Kim, H.A. Antibiotic Resistance and Clinical Presentation of Health Care-Associated Hypervirulent Klebsiella pneumoniae Infection in Korea. Microb. Drug Resist. 2019, 25, 1204–1209. [Google Scholar] [CrossRef] [PubMed]
- Liu, C.; Du, P.; Xiao, N.; Ji, F.; Russo, T.A.; Guo, J. Hypervirulent Klebsiella pneumoniae is emerging as an increasingly prevalent K. pneumoniae pathotype responsible for nosocomial and healthcare-associated infections in Beijing, China. Virulence 2020, 11, 1215–1224. [Google Scholar] [CrossRef] [PubMed]
- Shi, Q.; Lan, P.; Huang, D.; Hua, X.; Jiang, Y.; Zhou, J.; Yu, Y. Diversity of virulence level phenotype of hypervirulent Klebsiella pneumoniae from different sequence type lineage. BMC Microbiol. 2018, 18, 94. [Google Scholar] [CrossRef] [PubMed]
- Struve, C.; Roe, C.C.; Stegger, M.; Stahlhut, S.G.; Hansen, D.S.; Engelthaler, D.M.; Andersen, P.S.; Driebe, E.M.; Keim, P.; Krogfelt, K.A. Mapping the Evolution of Hypervirulent Klebsiella pneumoniae. mBio 2015, 6, e00630. [Google Scholar] [CrossRef] [PubMed]
- Yu, W.L.; Ko, W.C.; Cheng, K.C.; Lee, C.C.; Lai, C.C.; Chuang, Y.C. Comparison of prevalence of virulence factors for Klebsiella pneumoniae liver abscesses between isolates with capsular K1/K2 and non-K1/K2 serotypes. Diagn. Microbiol. Infect. Dis. 2008, 62, 1–6. [Google Scholar] [CrossRef]
- Harada, S.; Ishii, Y.; Saga, T.; Aoki, K.; Tateda, K. Molecular epidemiology of Klebsiella pneumoniae K1 and K2 isolates in Japan. Diagn. Microbiol. Infect. Dis. 2018, 91, 354–359. [Google Scholar] [CrossRef] [PubMed]
- Yeh, K.M.; Kurup, A.; Siu, L.K.; Koh, Y.L.; Fung, C.P.; Lin, J.C.; Chen, T.L.; Chang, F.Y.; Koh, T.H. Capsular serotype K1 or K2, rather than magA and rmpA, is a major virulence determinant for Klebsiella pneumoniae liver abscess in Singapore and Taiwan. J. Clin. Microbiol. 2007, 45, 466–471. [Google Scholar] [CrossRef]
- Catalan-Najera, J.C.; Garza-Ramos, U.; Barrios-Camacho, H. Hypervirulence and hypermucoviscosity: Two different but complementary Klebsiella spp. phenotypes? Virulence 2017, 8, 1111–1123. [Google Scholar] [CrossRef] [PubMed]
- Bialek-Davenet, S.; Criscuolo, A.; Ailloud, F.; Passet, V.; Jones, L.; Delannoy-Vieillard, A.S.; Garin, B.; Le Hello, S.; Arlet, G.; Nicolas-Chanoine, M.H.; et al. Genomic definition of hypervirulent and multidrug-resistant Klebsiella pneumoniae clonal groups. Emerg. Infect. Dis. 2014, 20, 1812–1820. [Google Scholar] [CrossRef] [PubMed]
- Passet, V.; Brisse, S. Association of tellurite resistance with hypervirulent clonal groups of Klebsiella pneumoniae. J. Clin. Microbiol. 2015, 53, 1380–1382. [Google Scholar] [CrossRef] [PubMed]
- McCabe, W.R. Endotoxin and bacteremia due to gram-negative organisms. N. Engl. J. Med. 1970, 283, 1342–1343. [Google Scholar] [CrossRef] [PubMed]
- Fang, C.T.; Chuang, Y.P.; Shun, C.T.; Chang, S.C.; Wang, J.T. A novel virulence gene in Klebsiella pneumoniae strains causing primary liver abscess and septic metastatic complications. J. Exp. Med. 2004, 199, 697–705. [Google Scholar] [CrossRef] [PubMed]
- Lan, P.; Yan, R.; Lu, Y.; Zhao, D.; Shi, Q.; Jiang, Y.; Yu, Y.; Zhou, J. Genetic diversity of siderophores and hypermucoviscosity phenotype in Klebsiella pneumoniae. Microb. Pathog. 2021, 158, 105014. [Google Scholar] [CrossRef] [PubMed]
- Dorman, M.J.; Feltwell, T.; Goulding, D.A.; Parkhill, J.; Short, F.L. The Capsule Regulatory Network of Klebsiella pneumoniae Defined by density-TraDISort. mBio 2018, 9, e01863-18. [Google Scholar] [CrossRef] [PubMed]
- Xu, Q.; Yang, X.; Chan, E.W.C.; Chen, S. The hypermucoviscosity of hypervirulent K. pneumoniae confers the ability to evade neutrophil-mediated phagocytosis. Virulence 2021, 12, 2050–2059. [Google Scholar] [CrossRef] [PubMed]
- Palacios, M.; Miner, T.A.; Frederick, D.R.; Sepulveda, V.E.; Quinn, J.D.; Walker, K.A.; Miller, V.L. Identification of Two Regulators of Virulence That Are Conserved in Klebsiella pneumoniae Classical and Hypervirulent Strains. mBio 2018, 9, e01443-18. [Google Scholar] [CrossRef] [PubMed]
- Choby, J.E.; Howard-Anderson, J.; Weiss, D.S. Hypervirulent Klebsiella pneumoniae—Clinical and molecular perspectives. J. Intern Med. 2020, 287, 283–300. [Google Scholar] [CrossRef] [PubMed]
- Russo, T.A.; Olson, R.; Macdonald, U.; Metzger, D.; Maltese, L.M.; Drake, E.J.; Gulick, A.M. Aerobactin mediates virulence and accounts for increased siderophore production under iron-limiting conditions by hypervirulent (hypermucoviscous) Klebsiella pneumoniae. Infect. Immun. 2014, 82, 2356–2367. [Google Scholar] [CrossRef] [PubMed]
- Koczura, R.; Kaznowski, A. Occurrence of the Yersinia high-pathogenicity island and iron uptake systems in clinical isolates of Klebsiella pneumoniae. Microb. Pathog. 2003, 35, 197–202. [Google Scholar] [CrossRef] [PubMed]
- Lee, C.R.; Lee, J.H.; Park, K.S.; Jeon, J.H.; Kim, Y.B.; Cha, C.J.; Jeong, B.C.; Lee, S.H. Antimicrobial Resistance of Hypervirulent Klebsiella pneumoniae: Epidemiology, Hypervirulence-Associated Determinants, and Resistance Mechanisms. Front. Cell. Infect. Microbiol. 2017, 7, 483. [Google Scholar] [CrossRef] [PubMed]
- Li, G.; Sun, S.; Zhao, Z.Y.; Sun, Y. The pathogenicity of rmpA or aerobactin-positive Klebsiella pneumoniae in infected mice. J. Int. Med. Res. 2019, 47, 4344–4352. [Google Scholar] [CrossRef] [PubMed]
- Gao, Q.; Shen, Z.; Qin, J.; Liu, Y.; Li, M. Antimicrobial Resistance and Pathogenicity Determination of Community-Acquired Hypervirulent Klebsiella pneumoniae. Microb. Drug Resist. 2020, 26, 1195–1200. [Google Scholar] [CrossRef] [PubMed]
- Lee, C.H.; Liu, J.W.; Su, L.H.; Chien, C.C.; Li, C.C.; Yang, K.D. Hypermucoviscosity associated with Klebsiella pneumoniae-mediated invasive syndrome: A prospective cross-sectional study in Taiwan. Int. J. Infect. Dis. 2010, 14, e688–e692. [Google Scholar] [CrossRef] [PubMed]
- Lederman, E.R.; Crum, N.F. Pyogenic liver abscess with a focus on Klebsiella pneumoniae as a primary pathogen: An emerging disease with unique clinical characteristics. Am. J. Gastroenterol. 2005, 100, 322–331. [Google Scholar] [CrossRef] [PubMed]
- Pomakova, D.K.; Hsiao, C.B.; Beanan, J.M.; Olson, R.; MacDonald, U.; Keynan, Y.; Russo, T.A. Clinical and phenotypic differences between classic and hypervirulent Klebsiella pneumonia: An emerging and under-recognized pathogenic variant. Eur. J. Clin. Microbiol. Infect. Dis. 2012, 31, 981–989. [Google Scholar] [CrossRef] [PubMed]
- Yeh, K.M.; Chiu, S.K.; Lin, C.L.; Huang, L.Y.; Tsai, Y.K.; Chang, J.C.; Lin, J.C.; Chang, F.Y.; Siu, L.K. Surface antigens contribute differently to the pathophysiological features in serotype K1 and K2 Klebsiella pneumoniae strains isolated from liver abscesses. Gut Pathog. 2016, 8, 4. [Google Scholar] [CrossRef] [PubMed]
- Cubero, M.; Grau, I.; Tubau, F.; Pallares, R.; Dominguez, M.A.; Linares, J.; Ardanuy, C. Hypervirulent Klebsiella pneumoniae clones causing bacteraemia in adults in a teaching hospital in Barcelona, Spain (2007–2013). Clin. Microbiol. Infect. 2016, 22, 154–160. [Google Scholar] [CrossRef] [PubMed]
- Zhang, Y.; Sun, J.; Mi, C.; Li, W.; Zhao, S.; Wang, Q.; Shi, D.; Liu, L.; Ding, B.; Chang, Y.F.; et al. First report of two rapid-onset fatal infections caused by a newly emerging hypervirulent K. Pneumonia ST86 strain of serotype K2 in China. Front. Microbiol. 2015, 6, 721. [Google Scholar] [CrossRef] [PubMed]
- Wu, M.C.; Lin, T.L.; Hsieh, P.F.; Yang, H.C.; Wang, J.T. Isolation of genes involved in biofilm formation of a Klebsiella pneumoniae strain causing pyogenic liver abscess. PLoS ONE 2011, 6, e23500. [Google Scholar] [CrossRef] [PubMed]
- Zhang, S.; Zhang, X.; Wu, Q.; Zheng, X.; Dong, G.; Fang, R.; Zhang, Y.; Cao, J.; Zhou, T. Clinical, microbiological, and molecular epidemiological characteristics of Klebsiella pneumoniae-induced pyogenic liver abscess in southeastern China. Antimicrob. Resist. Infect. Control 2019, 8, 166. [Google Scholar] [CrossRef] [PubMed]
- Holt, K.E.; Wertheim, H.; Zadoks, R.N.; Baker, S.; Whitehouse, C.A.; Dance, D.; Jenney, A.; Connor, T.R.; Hsu, L.Y.; Severin, J.; et al. Genomic analysis of diversity, population structure, virulence, and antimicrobial resistance in Klebsiella pneumoniae, an urgent threat to public health. Proc. Natl. Acad. Sci. USA 2015, 112, E3574–E3581. [Google Scholar] [CrossRef] [PubMed]
- Bilal, S.; Volz, M.S.; Fiedler, T.; Podschun, R.; Schneider, T. Klebsiella pneumoniae-induced liver abscesses, Germany. Emerg. Infect. Dis. 2014, 20, 1939–1940. [Google Scholar] [CrossRef] [PubMed]
- Cubero, M.; Marti, S.; Dominguez, M.A.; Gonzalez-Diaz, A.; Berbel, D.; Ardanuy, C. Hypervirulent Klebsiella pneumoniae serotype K1 clinical isolates form robust biofilms at the air-liquid interface. PLoS ONE 2019, 14, e0222628. [Google Scholar] [CrossRef] [PubMed]
- Liao, C.H.; Huang, Y.T.; Chang, C.Y.; Hsu, H.S.; Hsueh, P.R. Capsular serotypes and multilocus sequence types of bacteremic Klebsiella pneumoniae isolates associated with different types of infections. Eur. J. Clin. Microbiol. Infect. Dis. 2014, 33, 365–369. [Google Scholar] [CrossRef] [PubMed]
- Guo, Y.; Wang, S.; Zhan, L.; Jin, Y.; Duan, J.; Hao, Z.; Lv, J.; Qi, X.; Chen, L.; Kreiswirth, B.N.; et al. Microbiological and Clinical Characteristics of Hypermucoviscous Klebsiella pneumoniae Isolates Associated with Invasive Infections in China. Front. Cell. Infect. Microbiol. 2017, 7, 24. [Google Scholar] [CrossRef] [PubMed]
- Nassif, X.; Fournier, J.M.; Arondel, J.; Sansonetti, P.J. Mucoid phenotype of Klebsiella pneumoniae is a plasmid-encoded virulence factor. Infect. Immun. 1989, 57, 546–552. [Google Scholar] [CrossRef] [PubMed]
- Cheng, H.Y.; Chen, Y.S.; Wu, C.Y.; Chang, H.Y.; Lai, Y.C.; Peng, H.L. RmpA regulation of capsular polysaccharide biosynthesis in Klebsiella pneumoniae CG43. J. Bacteriol. 2010, 192, 3144–3158. [Google Scholar] [CrossRef] [PubMed]
- Lin, Z.W.; Zheng, J.X.; Bai, B.; Xu, G.J.; Lin, F.J.; Chen, Z.; Sun, X.; Qu, D.; Yu, Z.J.; Deng, Q.W. Characteristics of Hypervirulent Klebsiella pneumoniae: Does Low Expression of rmpA Contribute to the Absence of Hypervirulence? Front. Microbiol. 2020, 11, 436. [Google Scholar] [CrossRef] [PubMed]
- Tan, T.Y.; Ong, M.; Cheng, Y.; Ng, L.S.Y. Hypermucoviscosity, rmpA, and aerobactin are associated with community-acquired Klebsiella pneumoniae bacteremic isolates causing liver abscess in Singapore. J. Microbiol. Immunol. Infect. 2019, 52, 30–34. [Google Scholar] [CrossRef] [PubMed]
- Qu, T.T.; Zhou, J.C.; Jiang, Y.; Shi, K.R.; Li, B.; Shen, P.; Wei, Z.Q.; Yu, Y.S. Clinical and microbiological characteristics of Klebsiella pneumoniae liver abscess in East China. BMC Infect. Dis. 2015, 15, 161. [Google Scholar] [CrossRef] [PubMed]
- Yu, W.L.; Ko, W.C.; Cheng, K.C.; Lee, H.C.; Ke, D.S.; Lee, C.C.; Fung, C.P.; Chuang, Y.C. Association between rmpA and magA genes and clinical syndromes caused by Klebsiella pneumoniae in Taiwan. Clin. Infect. Dis. 2006, 42, 1351–1358. [Google Scholar] [CrossRef]

| CLA (−) (n = 380) | CLA (+) (n = 34) | p Value | |
|---|---|---|---|
| Epidemiology | |||
| Male sex | 223 (58.7) | 25 (73.5) | 0.091 |
| Age (years) | 67.9 ± 13.6 | 66.6 ± 10.9 | 0.577 |
| Underlying diseases | |||
| Solid tumor | 115 (30.3) | 4 (11.8) | 0.022 |
| Chronic liver disease | 45 (11.8) | 5 (14.7) | 0.585 |
| Neurological disease | 162 (42.6) | 7 (20.6) | 0.012 |
| Chronic renal disease | 39 (10.3) | 0 (0.0) | 0.060 |
| Diabetes mellitus | 133 (35.0) | 13 (38.2) | 0.705 |
| Chronic lung disease | 40 (10.5) | 2 (5.9) | 0.558 |
| Solid-organ transplantation | 12 (3.2) | 0 (0.0) | 0.610 |
| McCabe classification | |||
| Nonfatal underlying disease | 282 (74.2) | 33 (97.1) | 0.004 * |
| Ultimately fatal disease | 95 (25.0) | 1 (2.9) | |
| Fatal disease | 3 (0.8) | 0 (0.0) | |
| Predisposing factors | |||
| Urinary catheter | 184 (48.4) | 11 (32.4) | 0.072 |
| Percutaneous catheter drainage | 62 (16.3) | 26 (76.5) | <0.001 |
| L-tube | 92 (24.2) | 2 (5.9) | 0.015 |
| Invasive procedure | 91 (23.9) | 26 (76.5) | <0.001 |
| Recent operation | 72 (18.9) | 1 (2.9) | 0.019 |
| Prior ICU admission within 1 month | 55 (14.5) | 0 (0.0) | 0.014 * |
| Category of infection | |||
| Community-acquired infection | 133 (35.0) | 34 (100.0) | <0.001 |
| Healthcare-associated infection | 80 (21.1) | 0 (0.0) | |
| Nosocomial infection | 167 (43.9) | 0 (0.0) | |
| Infection source | |||
| Urinary tract infection | 88 (23.2) | 0 (0.0) | 0.002 |
| Intra-abdominal infection | 38 (10.0) | 34 (100.0) | <0.001 |
| Respiratory infection | 163 (42.9) | 0 (0.0) | <0.001 |
| Clinical presentation | |||
| Severe sepsis and septic shock | 125 (32.9) | 9 (26.5) | 0.443 |
| Metastatic infection | 4 (1.1) | 1 (2.9) | 0.351 |
| Concomitant bacteremia | 121 (31.8) | 21 (61.8) | <0.001 |
| Mechanical ventilation | 64 (16.8) | 3 (8.8) | 0.224 |
| Admission to ICU | 100 (26.3) | 6 (17.6) | 0.267 |
| Treatment outcomes | |||
| Treatment failure (72 h) | 68 (17.9) | 2 (5.9) | 0.073 |
| Infection-related 30-day mortality | 42 (13.7) | 2 (10.0) | 1.000 |
| Acute kidney injury | 46 (12.1) | 5 (14.7) | 0.592 |
| CLA (−) (n = 380) | CLA (+) (n = 34) | p Value | |
|---|---|---|---|
| Antimicrobial resistance rates | |||
| Amikacin | 19 (5.0) | 0 (0.0) | 0.387 |
| Amoxicillin/clavulanate | 122 (32.1) | 1 (2.9) | <0.001 |
| Aztreonam | 136 (35.8) | 1 (2.9) | <0.001 |
| Cefazolin | 139 (36.6) | 1 (2.9) | <0.001 |
| Cefepime | 134 (35.3) | 1 (2.9) | <0.001 |
| Cefotaxime | 136 (35.8) | 1 (2.9) | <0.001 |
| Ceftazidime | 136 (35.8) | 1 (2.9) | <0.001 |
| Ciprofloxacin | 111 (29.2) | 0 (0.0) | <0.001 |
| Ertapenem | 0 | 0 | n/a |
| Gentamicin | 70 (18.4) | 2 (5.9) | 0.065 |
| Imipenem | 0 | 0 | n/a |
| Piperacillin/tazobactam | 98 (25.8) | 2 (5.9) | 0.009 |
| Tigecycline | 43 (11.3) | 1 (2.9) | 0.156 |
| Trimethoprim/sulfamethoxazole | 101 (26.6) | 0 (0.0) | <0.001 |
| ESBL positivity | 134 (35.3) | 1 (2.9) | <0.001 |
| Serotype | |||
| K1 | 57 (15.0) | 20 (58.8) | <0.001 |
| K2 | 50 (13.2) | 9 (26.5) | 0.042 * |
| K5 | 3 (0.8) | 0 (0.0) | 1.000 |
| K20 | 19 (5.0) | 0 (0.0) | 0.387 |
| K54 | 4 (1.1) | 0 (0.0) | 1.000 |
| K57 | 16 (4.2) | 0 (0.0) | 0.383 |
| ND | 231 (60.8) | 5 (14.7) | <0.001 |
| Virulence gene | |||
| rmpA | 137 (36.1) | 28 (82.4) | <0.001 |
| magA | 47 (12.4) | 16 (47.1) | <0.001 |
| allS | 62 (16.4) | 18 (52.9) | <0.001 |
| mrkD | 370 (97.9) | 34 (100.0) | 1.000 |
| entB | 374 (98.9) | 34 (100.0) | 1.000 |
| kfu | 118 (31.2) | 20 (58.8) | 0.001 |
| Aerobactin | 143 (37.6) | 27 (79.4) | <0.001 |
| String test | 130 (34.2) | 25 (73.5) | <0.001 |
| Biofilm mass | 0.67 ± 0.46 | 0.98 ± 0.77 | 0.026 |
| >0.58 (median) | 177 (48.4) | 21 (61.8) | 0.135 |
| >0.80 | 111 (30.3) | 18 (52.9) | 0.007 |
| Variable | Univariate Analysis | Multivariate Analysis | ||||
|---|---|---|---|---|---|---|
| OR | 95% CI | p Value | OR | 95% CI | p Value | |
| String test (+) | 5.34 | 2.42–11.78 | <0.001 | − | − | − |
| iutA (+) | 6.39 | 2.71–15.06 | <0.001 | − | − | − |
| rmpA (+) | 8.28 | 3.34–20.49 | <0.001 | 5.83 | 2.15–15.78 | 0.001 |
| magA (+) | 6.30 | 3.01–13.19 | <0.001 | 2.34 | 1.01–5.40 | 0.047 |
| allS (+) | 5.73 | 2.77–11.86 | <0.001 | − | − | − |
| kfu (+) | 3.15 | 1.54–6.45 | 0.002 | − | − | − |
| Biofilm > 0.80 | 2.58 | 1.27–5.25 | 0.009 | 2.13 | 1.00–4.56 | 0.050 |
Disclaimer/Publisher’s Note: The statements, opinions and data contained in all publications are solely those of the individual author(s) and contributor(s) and not of MDPI and/or the editor(s). MDPI and/or the editor(s) disclaim responsibility for any injury to people or property resulting from any ideas, methods, instructions or products referred to in the content. |
© 2024 by the authors. Licensee MDPI, Basel, Switzerland. This article is an open access article distributed under the terms and conditions of the Creative Commons Attribution (CC BY) license (https://creativecommons.org/licenses/by/4.0/).
Share and Cite
Hyun, M.; Lee, J.Y.; Kim, H.A. Clinical and Microbiologic Analysis of Klebsiella pneumoniae Infection: Hypermucoviscosity, Virulence Factor, Genotype, and Antimicrobial Susceptibility. Diagnostics 2024, 14, 792. https://doi.org/10.3390/diagnostics14080792
Hyun M, Lee JY, Kim HA. Clinical and Microbiologic Analysis of Klebsiella pneumoniae Infection: Hypermucoviscosity, Virulence Factor, Genotype, and Antimicrobial Susceptibility. Diagnostics. 2024; 14(8):792. https://doi.org/10.3390/diagnostics14080792
Chicago/Turabian StyleHyun, Miri, Ji Yeon Lee, and Hyun Ah Kim. 2024. "Clinical and Microbiologic Analysis of Klebsiella pneumoniae Infection: Hypermucoviscosity, Virulence Factor, Genotype, and Antimicrobial Susceptibility" Diagnostics 14, no. 8: 792. https://doi.org/10.3390/diagnostics14080792
APA StyleHyun, M., Lee, J. Y., & Kim, H. A. (2024). Clinical and Microbiologic Analysis of Klebsiella pneumoniae Infection: Hypermucoviscosity, Virulence Factor, Genotype, and Antimicrobial Susceptibility. Diagnostics, 14(8), 792. https://doi.org/10.3390/diagnostics14080792

